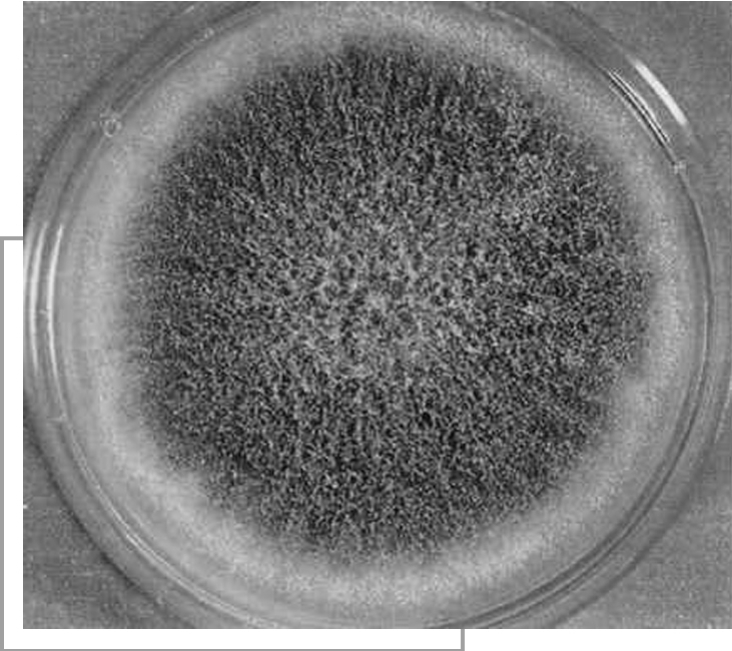

噪音污染与人体中的化学反应
环境污染与人体中的化学反应
食品污染与人体中的化学反应
食品中混进了对人体健康有害或有毒的物质,这种现象称为食品污染。污染食品的物质称为食品污染物。食用受污染的食品会对人体健康造成不同程度的危害。
食品污染可分为生物性污染、化学性污染和放射性污染。
(1)生物性污染:主要是由有害微生物及其毒素、寄生虫及其虫卵和昆虫等引起的。肉、鱼、蛋和奶等动物性食品易被致病菌及其毒素污染,导致食用者发生细菌性食物中毒和人畜共患的传染病。致病菌主要来自病人、带菌者和病畜、病禽等。致病菌及其毒素可通过空气、土壤、水、食具、患者的手或排泄物污染食品。被致病菌及其毒素污染的食品,特别是动物性食品,如食用前未经必要的加热处理,会引起沙门氏菌或金黄色葡萄球菌毒素等细菌性食物中毒。食用被污染的食品还可引起炭疽、结核和布氏杆菌病(波状热)等传染病。
霉菌广泛分布于自然界。受霉菌污染的农作物、空气、土壤和容器等都可使食品受到污染。部分霉菌菌株在适宜条件下,能产生有毒代谢产物,即霉菌毒素(见霉菌污染对健康的影响)。如黄曲霉毒素和单端孢霉菌毒素,对人畜都有很强的毒性。一次大量摄入被霉菌及其毒素污染的食品,会造成食物中毒;长期摄入小量受污染食品也会引起慢性病或癌症。有些霉菌毒素还能从动物或人体转入乳汁中,损害饮奶者的健康。
微生物含有可分解各种有机物的酶类。这些微生物污染食品后,在适宜条件下大量生长繁殖,食品中的蛋白质、脂肪和糖类,可在各种酶的作用下分解,使食品感官性状恶化,营养价值降低,甚至腐败变质。
污染食品的寄生虫主要有绦虫、旋毛虫、中华枝睾吸虫和蛔虫等。污染源主要是病人、病畜和水生物。污染物一般是通过病人或病畜的粪便污染水源或土壤,然后再使家畜、鱼类和蔬菜受到感染或污染。
粮食和各种食品的贮存条件不良,容易孳生各种仓储害虫。例如粮食中的甲虫类、蛾类和螨类;鱼、肉、酱或咸菜中的蝇蛆以及咸鱼中的干酷蝇幼虫等。枣、栗、饼干、点心等含糖较多的食品特别容易受到侵害。昆虫污染可使大量食品遭到破坏,但尚未发现受昆虫污染的食品对人体健康造成显著的危害。
(2)化学性污染:主要指农用化学物质、食品添加剂、食品包装容器和工业废弃物的污染,汞、镉、铅、砷、氰化物、有机磷、有机氯、亚硝酸盐和亚硝胺及其他有机或无机化合物等所造成的污染。造成化学性污染的原因有以下几种:①农业用化学物质的广泛应用和使用不当。②使用不合卫生要求的食品添加剂。③使用质量不合卫生要求的包装容器,造成容器上的可溶性有害物质在接触食品时进入食品,如陶瓷中的铅、聚氯乙烯塑料中的氯乙烯单体都有可能转移进入食品。又如包装蜡纸上的石蜡可能含有苯并(a)芘,彩色油墨和印刷纸张中可能含有多氯联苯,它们都特别容易向富含油脂的食物中移溶。④工业的不合理排放所造成的环境污染,也会通过食物链危害人体健康。
(3)放射性污染:食品中的放射性物质有来自地壳中的放射性物质,称为天然本底;也有来自核武器试验或和平利用放射能所产生的放射性物质,即人为的放射性污染(见放射性污染对健康的影响)。某些鱼类能富集金属同位素,如137铯和90锶等。后者半衰期较长,多富集于骨组织中,而且不易排出,对机体的造血器官有一定的影响。某些海产动物,如软体动物能富集90锶,牡蛎能富集大量65锌,某些鱼类能富集55铁。
对人体健康的危害有多方面的表现。一次大量摄入受污染的食品,可引起急性中毒,即食物中毒,如细菌性食物中毒、农药食物中毒和霉菌毒素中毒等。长期(一般指半年到1年以上)少量摄入含污染物的食品,可引起慢性中毒。造成慢性中毒的原因较难追查,而影响又更广泛,所以应格外重视。例如,摄入残留有机汞农药的粮食数月后,会出现周身乏力、尿汞含量增高等症状;长期摄入微量黄曲霉毒素污染的粮食,能引起肝细胞变性、坏死、脂肪浸润和胆管上皮细胞增生,甚至发生癌变。慢性中毒还可表现为生长迟缓、不孕、流产、死胎等生育功能障碍,有的还可通过母体使胎儿发生畸形。已知与食品有关的致畸物质有醋酸苯汞、甲基汞、2,4-滴、2,4,5-涕中的杂质四氯二苯二
英、狄氏剂、艾氏剂、DDT、氯丹、七氯和敌枯双等。
某些食品污染物还具有致突变作用。突变如发生在生殖细胞,可使正常妊娠发生障碍,甚至不能受孕,胎儿畸形或早死。突变如发生在体细胞,可使在正常情况下不再增殖的细胞发生不正常增殖而构成癌变的基础。与食品有关的致突变物有苯并(a)芘、黄曲霉毒素、DDT、狄氏剂和烷基汞化合物等。
以下几类食品污染物可诱发癌肿:
1.强致癌物质——3,4—苯并芘

烧烤类食品含有强致癌物质苯并芘
科学家研究发现,危害人类最严重的疾病之一——癌症,有80%~90%是环境因素引起的。而在致癌因素中,又有70%~90%是环境、食物、药物中的化学物质引起的。在已经发现的400多种致癌物质中,毒性最强的一种是3,4—苯并芘,它主要存在于煤、石油、焦油和沥青中。燃煤烟尘中的3,4—苯并芘含量较高,每燃烧1千克煤,约产生0.19~0.22毫克的3,4—苯并芘。一般的汽车每小时排出的废气中,约有0.25~0.32毫克的3,4—苯并芘。排入大气的3,4—苯并芘被吸附在飘尘中或降落到土壤和水体中,通过呼吸或饮食进入人体致癌。所以,有人喜欢在马路上跑步或在沥青路上翻晒粮食,就会吸入或受到3,4—苯并芘的污染。油煎烧焦的鱼肉或其他肉类中,也含有较多的3,4—苯并芘。有人烧油时喜欢让油冒烟或快起火时才放炒菜,认为这样可破坏油中的有害物质,这是不科学的。
为了防止产生3,4—苯并芘,还应不吸烟,因每100支香烟中约含3,4—苯并芘3.5~4.5毫克。
要防止3,4—苯并芘的危害,应对煤烟除尘,安装汽车排气净化装置和采取戒烟等措施。家庭中煤气灶的发展,也使家庭小环境污染加剧,所以安装抽油烟机是十分必要的。
2.易致癌物——亚硝胺
亚硝胺是一种常见的化学物质。有人对100多种亚硝胺化合物作动物试验,发现80多种能致癌,其中最强的是二甲基亚硝胺和二乙基亚硝胺。主要致癌器官是肝、胃和食道。
食品中的亚硝胺是由二级胺(仲胺)和亚硝酸盐在食品内或体内生成。二级胺主要来自蛋白质的分解和某些药物的残留;硝酸盐通过细菌亚硝化产生亚硝酸盐。食品中的硝酸盐是化肥残留或以防腐剂的形式加入。我们平时食用的腌肉、罐头食品以及许多为了保鲜的食品中都加入了防腐剂,这些防腐剂大多为硝酸盐。

腌菜中含有亚硝胺
据了解,智利人患胃癌率的比例在世界上是比较高的。经研究后认为,这与智利农业上大量施硝酸盐化肥,以及食品中亚硝酸盐含量高有关。在我国,解放以后发现,河南林县、四川西北部地区居民食管癌发病率很高。调查后发现,这些地区人食用新鲜蔬菜少,而在一年中,大多时间都食用腌咸菜和酸菜。腌菜中亚硝酸盐含量高,与胃癌、食管癌发病率成正比关系。
经常食用新鲜蔬菜、水果,是防止亚硝酸盐在体内合成的有效方法。
3.致癌祸首——黄曲霉素
黄曲霉素是黄曲霉真菌的代谢产物。黄曲霉在温热、潮湿的条件下生长迅速。花生、花生油、玉米、大米中均有,麦子和豆类中则少见。
黄曲霉素的致癌性是已知化学致癌物中最强的一种。1960年英国发生10万头火鸡吃了霉变的花生饼粕后大量中毒死亡的事件,就与黄曲霉菌有关。印度某农村曾发生食甩霉变玉米,引起397人发生中毒性肝炎病,最后死亡106人的严重事件。从非洲、泰国、肯尼亚等地的调查资料中显示,凡受黄曲霉毒污染严重的地区,肝癌的发病率明显增高。日本从霉米中分离出可诱发肝细胞瘤和肝细胞癌的多种毒霉菌和毒素。我国南方高温高湿地区的大米中,也存在类似情况。
致癌祸首——黄曲霉素
黄曲霉菌能耐较高的温度,一般的食物经蒸煮不易除去。人们通常采用在食物(花生、玉米等)未加热前,进行仔细冲洗,这样做可除去95%以上的霉菌。有人在加热或煮泡这些食物时,放一些碱,也是行之有效的方法之一。
需要指出的是有人认为,带黄曲霉菌的食物只要经油炸之后,食用就安全了。其实不然,油炸后虽然食物内的黄曲霉菌死了,但其菌体仍留在食物内,这样的食物食用后仍是不安全的。所以防止粮油作物霉变,才是预防黄曲霉素毒害的最好办法。
室内空气污染与人体中的化学反应
1.什么是室内空气污染
室内空气污染是指有害的化学性因子、物理性因子和(或)生物性因子进入室内空气中并已达到对人体身心健康产生直接或间接,近期或远期,或者潜在有害影响的程度的状况。“室内”主要指居室内,广义上也可泛指各种建筑物内,如办公楼、会议厅、医院、教室、旅馆、图书馆、展览厅、影剧院、体育馆、健身房、商场、地下铁道、候车室、候机厅等各种室内公共场所和公众事务场所内。有些国家还包括室内的生产环境。
人们对室内空气中的传染病病原体认识较早,而对其他有害因子则认识较少。其实,早在人类住进洞穴并在其内点火烤食取暖的时期,就有烟气污染。但当时这类影响的范围极小,持续时间极短暂,人的室外活动也极频繁,因此,室内空气污染无明显危害。随着人类文明的高度发展,尤其进入20世纪中叶以来,由于民用燃料的消耗量增加、进入室内的化工产品和电器设备的种类和数量增多,更由于为了节约能源寒冷地区的房屋建造得更加密闭,室内污染因子日渐增多而通风换气能力却反而减弱,这使得室内有些污染物的浓度较室外高达数十倍以上。

初装修的房屋应警惕室内空气污染
人们每天平均大约有80%以上的时间在室内度过。随着生产和生活方式的更加现代化,更多的工作和文娱体育活动都可在室内进行,购物也不必每天上街,合适的室内微小气候使人们不必经常到户外去调节热效应,这样,人们的室内活动时间就更多,甚至高达93%以上。因此,室内空气质量对人体健康的关系就显得更加密切更加重要。虽然室内污染物的浓度往往较低,但由于接触时间很长,故其累积接触量很高。尤其是老、幼、病、残等体弱人群机体抵抗力较低、户外活动机会更少,因此,室内空气质量的好坏与他们的关系尤为重要。
2.室内空气污染的分类
室内空气污染物的来源大致分成3类。
室内的人为活动产生的有害因子:人们在室内进行生理代谢,进行日常生活、工作学习等活动,这些可产生出很多污染因子。主要有以下几个方面:
(1)呼出气。呼出气的主要成分是CO2(二氧化碳)。每个成年人每小时平均呼出的CO2大约为22.6升。此外,伴随呼出的还可有氨、二甲胺、二乙胺、二乙醇、甲醇、丁烷、丁烯、二丁烯、乙酸、丙酮、氮氧化物、CO(一氧化碳)、H2S(硫化氢)、酚、苯、甲苯、CS2(二硫化碳)等。其中,大多数是体内的代谢产物,另一部分是吸入后仍以原形呼出的污染物。
(2)吸烟。这是室内主要的污染源之一。烟草燃烧产生的烟气,主要成分有CO、烟碱(尼古丁)、多环芳烃、甲醛、氮氧化物、亚硝胺、丙烯腈、氟化物、氰氢酸、颗粒物以及含砷、镉、镍、铅等的物质。总共约3000多种,其中具有致癌作用的约40多种。吸烟是肺癌的主要病因之一。
(3)燃料燃烧。也是室内主要污染源之一。不同种类的燃料,甚至不同产地的同类燃料,其化学组成以及燃烧产物的成分和数量都会不同。但总的来看,煤的燃烧产物以颗粒物、SO2(二氧化硫)、NO2(二氧化氮)、CO、多环芳烃为主;液化石油气的燃烧产物以NO2、CO、多环芳烃、甲醛为主。蜂窝煤在无烟囱的炉子内旺盛燃烧,厨房空气中SO2可达17毫克/米3,通常在3毫克/米3左右;NO2可高达50毫克/米3,通常在4毫克/米3左右;CO可达300毫克/米3以上,通常约20~30毫克/米3;颗粒物约在1~2毫克/米3。有烟囱时,SO2可降至约在0.05毫克/米3;NO2在0.6毫克/米3左右;CO约6毫克/米3;颗粒物约1.4毫克/米3。液化石油气燃烧充分而室内无抽气设备时,SO2由未检出至0.05毫克/米3;NO2为10毫克/米3以上;CO为3~4毫克/米3;颗粒物为0.26毫克/米3;甲醛可达0.1~0.4毫克/米3。
3.室内空气污染对人体伤害
SO2和NO2对呼吸道有损伤。CO除引起急性中毒外,其慢性影响为损伤心肌和中枢神经。颗粒物中含有大量的多环芳烃(PAH),其中有很多是致癌原。例如,3,4-苯并[a]芘的某些代谢中间产物的致癌性就很强。从1775年P·波特发现英国扫烟囱工人易患阴囊癌开始,人们逐渐认识到煤焦油中有致癌物。20世纪80年代对云南省宣威县肺癌高发原因的研究,证明了当地燃煤的烟气中,含有大量致癌的PAH。另一项流行学调查发现,北方非肺癌高发地区的农民肺癌原因之一是冬季家中燃烧蜂窝煤而不安装烟囱。液化石油气燃烧颗粒物的二氯甲烷提取物中,含有硝基多环芳烃,这是一种强致突变物。
此外,某些地区的煤中含有较多的氟、砷等无机污染物,燃烧时能污染室内空气和食物,吸入或食入后,能引起氟中毒或砷中毒。
烹调。烹调产生的油烟不仅有碍一般卫生,更重要的是其中含有致突变物。
室内不清洁,致敏性生物滋生。主要的室内致敏生物是真菌和尘螨。主要来自家禽、尘土等。真菌的滋生能力很强,只要略有水分和有机物,即能生长。例如玻璃表面、家用电器内部、墙缝里、木板上,甚至喷气式飞机的高级汽油筒的塞子上也能生长。尘螨喜潮湿温暖,主要生长在尘埃、床垫、枕头、沙发椅、衣服、食物等处。无论是活螨还是死螨,甚至其蜕皮或排泄物,都具有抗原性,能引起哮喘或荨麻疹。
病人传播病原体。患有呼吸道传染病的病人,通过呼出气、喷嚏、咳嗽、痰和鼻涕等,可将病原体传播给他人。
室内使用的复印机、静电除尘器等仪器设备产生臭氧(O3)。O3是一种强氧化剂。对呼吸道有刺激作用,尤其能损伤肺泡。
家用电器产生电磁辐射。如果辐射强度很大,也会使人头晕、嗜唾、无力、记忆力衰退。
室内的尘埃、燃烧颗粒物、飞沫等污染物,与室内的空气轻离子结合,形成重离子。前者在污浊空气中仅能存留1分钟,而后者则能存留1小时,这样就加强了重正离子的不良影响:头痛、心烦、疲劳、血压升高、精神萎靡、注意力衰退、工作能力降低、失眠等。
室内物品中有害因子的直接散发。室内有很多物体和用品,其本身即含有各种有害因子,一旦暴露于空气中,就会散发出来造成危害。主要来自以下几方面:
建筑材料。某些水泥、砖、石灰等建筑材料的原材料中,本身就含有放射性镭。待建筑物落成后,镭的衰变物氡(222Rn)及其子体就会释放到室内空气中,进入人体呼吸道,是肺癌的病因之一。室外空气中氡含量约为10贝可/米3以下,室内严重污染时可超过数十倍。美国由氡及其子体引起的肺癌超额死亡人数为1万~2万。
使用脲—甲醛泡沫绝热材料(UFFI)的房屋,可释放出大量甲醛,有时可高达10毫克/米3以上。甲醛具有明显的刺激作用,对眼、喉、气管的刺激很大;在体内能形成变态原,引起支气管哮喘和皮肤的变态反应;能损伤肝脏,尤其是有肝炎既往史的人,住进UFFI活动房屋以后,容易复发肝炎。长期吸入低浓度甲醛,能引起头痛、头晕、恶心、呼吸困难、肺功能下降、神经衰弱,免疫功能也受影响。动物试验能诱发出鼻咽癌。尚未见到人体致癌的流行学证据。
有些建筑材料中含有石棉,可散发出石棉纤维。石棉能致肺癌,以及胸、腹膜间皮瘤。
家具、装饰用品和装潢摆设。常用的有地板革、地板砖、化纤地毯、塑料壁纸、绝热材料、脲—甲醛树脂黏合剂以及用该黏合剂黏制成的纤维板、胶合板等做成的家具等等都能释放多种挥发性有机化合物,主要是甲醛。中国沈阳市某新建高级宾馆内,甲醛浓度最高达1.11毫克/米3,普通居室内新装饰后可达0.17毫克/米3左右,以后渐减。此外,有些产品还能释放出苯、甲苯、二甲苯、CS2、三氯甲烷、三氯乙烯、氯苯等100余种挥发性有机物。其中有的能损伤肝脏、肾脏、骨髓、血液、呼吸系统、神经系统、免疫系统等,有的甚至能致敏、致癌。
日常生活和办公用品。例如化妆品、洗涤剂、清洁剂、消毒剂、杀虫剂、纺织品、油墨、油漆、染料、涂料等都会散发出甲醛和其他种类的挥发性有机化合物、表面活性剂等。这些都能通过呼吸道和皮肤影响人体。
从室外进入室内的污染物。室外环境中的一部分有害因子,也能通过各种适当的介质进入室内。常见以下情况:
当大气中的污染物高于室内浓度时,可通过门窗、缝隙等途径进入室内。例如颗粒物、SO2、NO2、多环芳烃以及其他有害气体。
土壤中含镭的地区,镭的衰变物氡及其子体可以通过房屋地基或房屋的管道入口处的缝隙进入室内。也可以先溶入地下水,当室内使用地下水时,即逸出到空气中。地下室或底层房间内空气中的氡浓度可达几百贝可/米3,楼层越高,浓度越低。
土壤中或天然水体中可含一种革兰阴性的杆菌,称为军团杆菌。可随空调冷却水,加湿器用水甚至淋浴喷头的水柱进入室内形成气溶胶,进入人体呼吸道造成肺部感染,称为军团病(嗜肺炎军团杆菌病)。
人为带入。服装、用具等可将工作环境或其他室外环境中的污染物(如铅尘)带入室内。
除了以上方面的来源以外,还有一些其他来源。例如,紫外线的光化学作用可以产生臭氧。
总之,室内空气污染物的来源很广、种类很多,对人体健康可以造成多方面的危害。而且,污染物往往可以若干种类同时存在于室内空气中,可以同时作用于人体而产生联合有害影响。(https://www.daowen.com)
人体对室内空气污染物接触量的评价。可以采用个体采样器进行采样测定,从而掌握个人的环境接触量。也可以进行人体的生物材料监测,即选择性地测定呼出气、血、尿或毛发中的污染物含量,从而了解人体内的实际吸收量。
污染物的室内实际浓度,主要取决于污染源的排出量。此外,还与气象因子、室内通风效果、污染物自身演变转化的规律有关。
有些国家已制定了几项室内污染物的卫生标准。中国已正式公布公共场所卫生管理条例,尚未公布其他的有关室内空气质量的卫生标准。
室内空气污染的防治措施。主要是消除或控制污染源;加强室内自然通风或机械通风;对能散发出有害因子的物品尽可能放置于室外若干时间,待充分散发后再放置室内。
生活污染与人体中的化学反应
1.伦敦烟雾事件

伦敦烟雾事件
伦敦是一座拥有2000多年历史的大城市,地处泰晤士河流域开阔的河谷地区。1952年12月5~8日,正值隆冬季节,伦敦受反气旋气候影响,浓雾覆盖,温度骤降。空气静止、浓雾不散、黑云压城,整个伦敦市淹没在浓重的烟雾之中。与此同时,工厂和住家成千上万个烟囱照样向天空排放着大量的黑烟。它们在天空中集聚,无法扩散,使空气中污染物浓度不断增加。烟尘浓度最高达到4.46毫克/米3,为平时的10倍;二氧化硫最高浓度达到1.34毫克/千克,为平时的6倍。伦敦市大街小巷都充满了煤烟、硫磺的气味,交通警察不得不戴上了防毒面具,来往行人则边走边用手帕捂鼻子、擦眼泪。悲剧终于发生了。一群准备在交易会上展出的得奖牛,它们呼吸困难、舌头吐露,其中1头当场死去,12头奄奄待毙,160头相继倒地抽搐,急需治疗。接踵而至的是,市民也难逃厄运,几千人感觉胸口闷得发慌,并伴有咳嗽、咽喉疼痛和呕吐。随之,老人、婴幼儿、病人的死亡数增加,到第三四天情况更趋严重,发病率、死亡率急剧上升,4天中共死亡4000人。据统计,45岁以上者死亡最多,约为平时的3倍;1岁以下的死亡者,约为平时的2倍。另据统计,发生事件的1周中,因支气管发炎死亡的为704人,是前周的9.3倍;冠心病患者死亡281人,是前周的2.4倍;心脏衰竭者死亡244人,是前周的2.8倍;肺结核患者死亡77人,是前周的5.5倍;肺炎、肺癌、流感及其他呼吸道患者的死亡率也都是成倍地增长。就是在事件过后的2个月内,还陆续死亡8000人。这就是震惊一时的伦敦烟雾事件。直到12月10日,一股轻快的西风吹来了北大西洋的新鲜空气,才驱散了弥漫在伦敦上空的毒雾,使人们重见天日,解除痛苦。
伦敦的烟雾事件由来已久。1873、1880和1891年就相继发生过3次由于燃煤而造成的毒雾事件,死亡人数共计约1800名。以后还发生过多次。当局对此不闻不问,以致问题越来越严重。1952年的事件再次发生后,英国社会哗然,纷纷要求政府当局对受害情况进行调查。但是,未能查清原因,也未采取有效防治措施,导致后来又相继发生几起烟雾事件。如1962年的一起,气候变化与1952年相似,空气中的二氧化硫浓度比1952年还高,只是烟尘浓度仅及1952年的1/2,才使死亡率比1952年低80%。英国当局再次在人民的压力下不得不进行深入研究,终于找到了伦敦烟雾事件的原因是:煤中含有三氧化二铁,它能促进空气中的二氧化硫氧化,生成硫酸液末,附着在烟尘上或凝聚在雾核上,进入人的呼吸系统,使人发病或加速慢性病患者的死亡。
2.洛杉矶光化学烟雾事件

洛杉矶光化学烟雾
洛杉矶是美国加利福尼亚州南部太平洋沿岸的滨海城市,常年阳光明媚、气候温和、风景优美,是人们的游览胜地。著名的电影中心好莱坞在它的西北郊。随着该地区石油工业的开发,飞机制造等军事工业的迅速发展,人口激增,洛杉矶已成为美国西部地区工商业重镇和著名海港。它从此也就失去了往昔的优美和宁静。目前有人口700多万,汽车数百万辆,每天耗费汽油600多万加仑(美制1加仑=3.785升),是世界上交通最繁忙的地方之一。
1943年以来,美国洛杉矶首次出现光化学烟雾。这是一种浅蓝色的刺激性烟雾。滞留在市内几天不散,大气可见度大为下降,许多居民眼红、鼻痛、喉头发炎,还伴有咳嗽和不同程度的头痛和胸痛、呼吸衰弱,不少老人经受不住折磨而死亡;同时,家畜患病、植物遭殃、橡胶制品老化、材料与建筑物受损。
对洛杉矶型烟雾的来源、形成的调查,可说是颇费周折,前后经过七八年时间。起初认为是二氧化硫造成的,因此当局采取措施,控制各有关工业部门二氧化硫的排放量。但是烟雾并未减少。后来发现石油挥发物(碳氢化合物)同二氧化氮或空气中的其他成分一起,在太阳光作用下,产生一种浅蓝色的烟雾,它不同于一般煤尘的烟雾,是光化学烟雾。当局为此禁止石油精炼厂储油罐挥发物排入大气,结果仍未使烟雾减少。最后从汽车排放物中找到了构成光化学烟雾的原因。当时洛杉矶有汽车250万辆,每天耗费汽油1600万升,因汽车汽化器的汽化效率低下,每天有1000多吨碳氢化合物排入大气中,在太阳光的作用下形成光化学烟雾。
洛杉矶型烟雾所以能形成,还有与其地理环境和气象条件有关。洛杉矶市区面临大洋,三面环山,形成一个直径约50千米的盆地。由于东南北三面山脉的阻碍,只有西面刮来海风,一年约有300天从西海岸到夏威夷群岛的北太平洋上空出现逆温层,如同盖子压在洛杉矶的上空,烟雾难以扩散。当逆温层高度为450米时,大气可见度下降,当逆温层高度为180米时,光化学烟雾就带到地面,扩散不开,形成污染。为此,每年5~10月期间,阳光强烈,烟雾就比较严重。汽车尾气多、盆地式地形、无风天气多,这就使洛杉矶很容易发生光化学烟雾。因它每年有60天烟雾尤为严重,故被称为美国的“烟雾城”。
对于光化学烟雾污染,美国目前还无法防治,洛杉矶的居民仍深受其害。再加上美国的生活方式,决定了各地的汽车有增无减,因此,几乎每座城市或轻或重地都受到洛杉矶型光化学烟雾的困扰。
3.日本熊本县水俣病事件
日本的水质污染与其工业的发展分不开。战后日本经济高速增长时期重点发展重化工业,它们排出的废水中含有大量的重金属、毒泥、多氯联苯、油和酚等,严重地污染了水质。工业废水的重金属主要是汞、镉等,它们经过生态系统食物链的富集,成千上万倍地在生物体内积累起来,这些生物体被鱼吞食后又在鱼体内进一步浓缩、富集,人们一旦食用了这些水产品就会慢性中毒。

水俣病
水俣是日本九州南部的一个小镇,属熊本县管辖。全镇有居民4万人,周围村庄还住着1万多农民和渔民。其西面是鱼产丰富的不知火海和水俣湾,因而渔业兴旺。1925年日本氮肥公司在此建厂,生产氮肥、醋酸乙烯、氯乙烯等,随着该企业的不断发展,给当地人民带来的灾难也开始降临。1950年在水俣湾附近的小渔村中,出现了一些疯猫,它们步态不稳、惊恐不安、抽筋麻痹,最后跳入水中溺死,被当地人称为“自杀猫”。当时这种狂猫跳海奇闻并未引起人们的关注。1953年在水俣镇出现了一个生怪病的人,开始只是口齿不清、步态不稳、面部痴呆,后来发展到耳聋眼瞎、全身麻木,最后神经失常,时而酣睡,时而无比兴奋,体如弯弓,高叫而死。1956年4月,一个6岁女孩因同样症状送入医院,初步诊断为脑系科疾癍;同年5月,又有4个同样病人入院就医,另外还有50多名患者没入院,这时才引起人们的关注。当地的熊本大学医学院与市医师会和医院组成水俣怪病对策委员会,开展调查。在调查中把疯猫和怪病人联系起来分析,确认这是由日氮公司水馔工厂排出的废水引起的。因为,该工厂在生产氯乙烯、醋黢乙烯时,采用低成本的汞催化剂(氯化汞和硫酸汞)工艺,把大量含有甲基汞的毒水废渣排入水俣湾和不知火海,殃及海中鱼虾。当地居民常年食用这种受污染的海产后,大脑和神经系统受到损伤,具体病症表现为眼神呆滞、常流口水、手足颤抖不已,发作起来即狂蹦乱跳。这是一种不治之症,轻者终生残疾,重者死亡。因这种怪病发生在水俣地区,故称为“水俣病”。
“水俣病”给人们带来无穷的灾难。首当其冲的是捕渔业。因为鱼有毒,居民不敢食用,企业开始倒闭,成千上万渔民被迫加入失业队伍。1958年春厂方为掩人耳目,将毒水排入水俣镇的北部,造成新的污染区。六七个月后,在那里又出现了18个汞中毒病人。当地居民要求政府调查此事,但厂方百般阻挠,地方当局态度暖昧,以致水俣病在日本各地迅速蔓延。1963年,日本西海岸的阿贺野川流域下游的新潟县内,出现大批的“自杀猫”、“自杀狗”。1964年8月当地猫的90%以上都“自杀”了,随之有死猫的居民也相继出现水俣病症状。短期内患者增加到45人,其中5人死亡,他们都是食用阿贺野川鱼最多的。这一事件是由昭和电器公司鹿濑工厂排放含汞废水引起的,因病症和“水俣病”相同,因此被称为“第二水俣病”。据1972年日本环境厅公布,日本熊本县水俣湾与新澙县阿贺野川两个地区共有汞中毒患者283人,其中60人已死亡,受害居民已达1万人左右。水俣病对人们的残害使好多家庭妻离子散、家破人亡。在日本的报刊杂志上迄今还时有水俣病后患的报道。
4.前苏联切尔诺贝利核事故
第二次世界大战中,美国在日本广岛、长崎两地投掷了2颗原子弹,迫使日本投降,为结束第二次世界大战起了重要作用。战后,人们从原子弹的巨大威力中也得到启发,开始和平利用原子能,为人类谋幸福。20世纪70年代两次石油危机,迫使世界各国为发展经济而制定能源多样化政策。由于核能干净、运输方便、富有经济性,各国竞相兴建核电站。截至80年代后半期,全世界约有370个核动力反应堆在运转,2000年核电占世界发电总量的20%以上。和平利用原子能已是时代的要求。但是,原子能进入人类生活后,从费尔米的第一座原子能装置开始运转到库尔恰托夫的第一座工业原子能发电站正式运行,类似广岛和长崎式的悲剧,犹如幽灵在人们身旁游荡。全世界曾发生过150多起核电站泄出放射性物质的事故,在美国、德国、英国、前苏联均曾发生过,有些事故十分严重。尤其是美国三里岛事件使人们谈核色变,前苏联的切尔诺贝利核事故更是后患无穷。
切尔诺贝利核电站在乌克兰境内,位于基辅北面。1986年4月26日该电站的第4号反应堆起火燃烧,整个反应堆浸泡在水里。这次事故规模之大、程度之严重、后果之深远,都是举世无双的。当时,第4号反应堆已烧毁,只能用混凝土将它埋起来。前苏联切尔诺贝利式反应堆共有15个,它们所生产的核能占全国核能产量的50%以上,每年发电量达28312兆瓦。而这些核电站设计时均无可以防止漏出的放射性物质逸入大气中的安全壳。据官方报道,切尔诺贝利核电站事故中仅有2人丧生。但据西方报道,死亡人数超近2000人。1992年6月基辅再次公布数字,承认已有6000~8000名乌克兰人死于切尔诺贝利的核辐射。该事故还严重污染着前苏联境内最肥沃地区。
奥夫鲁奇位于切尔诺贝利以西大约80千米,居住着8万人口,是一个田地平展的地区,松树和白桦树成林,农民在那里放牧奶牛,种植小麦和其他作物。但是核事故给这个田园诗般的画面带来了一场无尽无休的灾难:儿童生病、死亡率不断上升、动物令人吃惊地畸形,事故的遗患成了日常生活的组成部分。据乌克兰总统克拉夫丘克在奥夫鲁奇的代表伊万·奥克里姆丘克所说:“从我上午一开始工作,所做的每一件事都同切尔诺贝利有关。”奥夫鲁奇市政府咨询委员会成员和一家民间的辐射作用监督的积极分子阿纳托利·波尔希科夫也抱怨道:“当局使我们居住在有毒的领土上。”在该市第一幼儿园的有屋檐滴水的建筑物底部地面上,用γ射线探测器发现了比儿童安全标准高3倍的辐射作用热点。尽管该幼儿园早就由士兵洗刷过,但为了200名小孩的安全,必须把表土掘起并搬走。甚至有人断言:“从纯粹的医学观点看,所有的儿童都必须从奥夫鲁奇地区撤走。”据调查,1986~1990年该地区贫血病人增加了114%,肠胃不适的人增加了3.5倍;尤其是儿童的健康遭到极大的伤害,在某些年龄组的小孩中有多达40%的人肺部免疫能力减弱,儿童得喉炎、支气管炎和其他肺部和呼吸道疾病的增加了4倍;青少年被列为“身体很不好”的人数增加了5倍,每年能拿到身体完全健康证书的儿童人数在持续下降。这种免疫系统受损被称为“切尔诺贝利艾滋病”。这并非危言耸听,自1989年以来,该地区的农庄牲畜畸形怪胎已增加了1倍。因为当地牧草和水面已受到铯、锶及其他同位素的污染,向人们提供干净的食品和水已变为官员们的首要任务,他们为每月需要大约6节火车车厢的进口牛奶及其他食品和饮用水而奔忙。但是,乌克兰因汽油短缺,无法定期向奥夫鲁奇153个村子供应食品。当地原有282名医生,因辐射危险只剩下142名,而且医学学校毕业生已不再愿意来此工作,苏联解体更造成抗生素、止痛药、麻醉剂的长期短缺。奥夫鲁奇人民处在极端的困境之中,但哪里也不愿接受这些“生态难民”。
切尔诺贝利核事故还殃及邻国。华沙离出事地点只有640千米,因此波兰电视台在同年4月29日即宣布对牛奶销售实行限制,说波兰东北地区的儿童有可能受到切尔诺贝利核事故的辐射污染。丹麦首相保罗·施吕特抱怨说:“苏联人丝毫不透露风声,真令人遗憾。”瑞典能源大臣比尔吉塔·达尔也警告说:“我们两国之间今后的关系将取决于莫斯科是否很乐意及时回答问题和对提高安全标准的要求作出反应。”由于捷克、斯洛伐克、保加利亚、匈牙利和前东德的核电力计划在很大程度上采用了前苏联技术,切尔诺贝利核事故使东欧处于一片恐慌之中。捷克有一座同切尔诺贝利相似的核电站距离维也纳只有30千米,这使奥地利人非常不满。芬兰购买了2座前苏联制造的反应堆,因它没有安全壳而使芬兰人惶惶不可终日。
噪音污染与人体中的化学反应
1.什么是噪声污染
随着近代工业的发展,环境污染也随着产生,噪声污染就是环境污染的一种,已经成为对人类的一大危害。噪声污染与水污染、大气污染被看成是世界范围内三个主要环境问题。
噪声是发生体做无规则振动时发出的声音。
声音由物体振动引起,以波的形式在一定的介质(如固体、液体、气体)中进行传播。我们通常听到的声音为空气声。一般情况下,人耳可听到的声波频率为20~20000赫兹,称为可听声;低于20赫兹,称为次声波;高于20000赫兹,称为超声波。我们所听到声音的音调的高低取决于声波的频率,高频声听起来尖锐,而低频声给人的感觉较为沉闷。声音的大小是由声音的强弱决定的。从物理学的观点来看,噪声是由各种不同频率、不同强度的声音杂乱、无规律的组合而成;乐音则是和谐的声音。
判断一个声音是否属于噪声,仅从物理学角度判断是不够的,主观上的因素往往起着决定性的作用。例如,美妙的音乐对正在欣赏音乐的人来说是乐音,但对于正在学习、休息或集中精力思考问题的人可能是一种噪声。即使同一种声音,当人处于不同状态、不同心情时,对声音也会产生不同的主观判断,此时声音可能成为噪声或乐音。因此,从生理学观点来看,凡是干扰人们休息、学习和工作的声音,即不需要的声音,统称为噪声。当噪声对人及周围环境造成不良影响时,就形成噪声污染。
2.噪声的分类
噪声污染按声源的机械特点可分为:气体扰动产生的噪声、固体振动产生的噪声、液体撞击产生的噪声以及电磁作用产生的电磁噪声。
噪声按声音的频率可分为:<400赫兹的低频噪声、400~1000赫兹的中频噪声及>1000赫兹的高频噪声。
噪声按时间变化的属性可分为:稳态噪声、非稳态噪声、起伏噪声、间歇噪声以及脉冲噪声等。
噪声有自然现象引起的(见自然界噪声),有人为造成的,故也分为自然噪声和人造噪声。
3.噪声的主要来源
(1)交通噪声
包括机动车辆、船舶、地铁、火车、飞机等发出的噪声。由于机动车辆数目的迅速增加,使得交通噪声成为城市的主要噪声来源。
(2)工业噪声
工厂的各种设备产生的噪声。工业噪声的声级一般较高,对工人及周围居民带来较大的影响。

噪声污染
(3)建筑噪声
主要来源于建筑机械发出的噪声。建筑噪声的特点是强度较大,且多发生在人口密集地区,因此严重影响居民的休息与生活。
(4)社会噪声
包括人们的社会活动和家用电器、音响设备发出的噪声。这些设备的噪声级虽然不高,但由于和人们的日常生活联系密切,使人们在休息时得不到安静,尤为让人烦恼,极易引起邻里纠纷。
噪声的特性
噪声既是一种公害,它就具有公害的特性,同时它作为声音的一种,也具有声学特性。
(1)噪声的公害特性
由于噪声属于感觉公害,所以它与其他有害有毒物质引起的公害不同。首先,它没有污染物,即噪声在空中传播时并未给周围环境留下什么毒害性的物质;其次,噪声对环境的影响不积累、不持久,传播的距离也有限;噪声声源分散,而且一旦声源停止发声,噪声也就消失。因此,噪声不能集中处理,需用特殊的方法进行控制。
(2)噪声的声学特性
简单地说,噪声就是声音,它具有一切声学的特性和规律。但是噪声对环境的影响和它的强弱有关,噪声愈强,影响愈大。衡量噪声强弱的物理量是噪声级。
5.噪声对人体健康的危害
噪声污染对人、动物、仪器仪表以及建筑物均构成危害,其危害程度主要取决于噪声的频率、强度及暴露时间。噪声危害主要包括:
因为噪声通过听觉器官作用于大脑中枢神经系统,以致影响到全身各个器官,故噪声除对人的听力造成损伤外,还会给人体其他系统带来危害。由于噪声的作用,会产生头痛、脑胀、耳鸣、失眠、全身疲乏无力以及记忆力减退等神经衰弱症状。长期在高噪声环境下工作的人与低噪声环境下的情况相比,高血压、动脉硬化和冠心病的发病率要高2~3倍。可见噪声会导致心血管系统疾病。噪声也可导致消化系统功能紊乱,引起消化不良、食欲不振、恶心呕吐,使肠胃病和溃疡病发病率升高。此外,噪声对视觉器官、内分泌机能及胎儿的正常发育等方面也会产生一定影响。在高噪声中工作和生活的人们,一般健康水平逐年下降,对疾病的抵抗力减弱,诱发一些疾病,但也和个人的体质因素有关,不可一概而论。
噪声是一类引起人烦躁,或音量过强而危害人体健康的声音。噪声污染主要来源于交通运输、车辆鸣笛、工业噪音、建筑施工、社会噪音如音乐厅、高音喇叭、早市和人的大声说话等。
噪声给人带来生理上和心理上的危害主要有以下几方面:损害听力。有检测表明,当人连续听摩托车声,8小时以后听力就会受损;若是在摇滚音乐厅,半小时后人的听力就会受损。有害于人的心血管系统。中国对城市噪声与居民健康的调查表明,地区的噪声每上升1分贝,高血压发病率就增加3%。影响人的神经系统,使人急躁、易怒。影响睡眠,造成疲倦。
从心理声学的角度来说,噪音又称噪声,一般是指不恰当或者不舒服的听觉刺激。它是一种由为数众多的频率组成的并具有非周期性振动的复合声音。简言之,噪音是非周期性的声音振动。它的音波波形不规则,听起来感到刺耳。从社会和心理意义来说,凡是妨碍人们学习、工作和休息并使人产生不舒适感觉的声音,都叫噪音。如流水声、敲打声、沙沙声,机器轰鸣声等,都是噪音。它的测量单位是分贝。零分贝是可听见音的最低强度。
噪声有高强度和低强度之分。低强度的噪声在一般情况下对人的身心健康没有什么害处,而且在许多情况下还有利于提高工作效率。高强度的噪声主要来自工业机器(如织布机、车床、空气压缩机、风镐、鼓风机等)、现代交通工具(如汽车、火车、摩托车、拖拉机、飞机等)、高音喇叭、建筑工地以及商场、体育和文娱场所的喧闹声等。这些高强度的噪声危害着人们的机体,使人感到疲劳,产生消极情绪,甚至引起疾病。
高强度的噪声,不仅损害人的听觉,而且对神经系统、心血管系统、内分泌系统、消化系统以及视觉、智力等都有不同程度的影响。如果人长期在95分贝的噪声环境里工作和生活,大约有29%的会丧失听力;即使噪声只有85分贝,也有10%的人会发生耳聋;120~130分贝的噪声,能使人感到耳内疼痛;更强的噪音会使听觉器官受到损害。在神经系统方面,强噪音会使人出现头痛、头晕、倦怠、失眠、情绪不安、记忆力减退等症候群,脑电图慢波增加,自主神经系统功能紊乱等;在心血管系统方面,强噪音会使人出现脉搏和心率改变,血压升高,心律不齐,传导阻滞,外周血流变化等;在内分泌系统方面,强噪音会使人出现甲状腺功能亢进,肾上腺皮质功能增强,基础代谢率升高,性功能紊乱,月经失调等;在消化系统方面,强噪音会使人出现消化机能减退,胃功能紊乱,胃酸减少,食欲不振等。总之,强噪音会导致人体一系列的生理、病理变化。有人曾对在噪音达95分贝的环境中工作的202人进行过调查,头晕的占39%,失眠的占32%,头痛的占27%,胃痛的占27%,心慌的占27%,记忆力衰退的占27%,心烦的占22%,食欲不佳的占18%,高血压的占12%。所以,我们不能对强噪音等闲视之,应采取措施加以防止。当然,人们对噪音比较敏感,各个体之间是有很大差异,有的人对噪音比较敏感,有的人对噪音有较强的适应性,也与人的需要、情绪等心理因素有关。不管人们之间的差异如何,对强噪音总是需要加以防止的。
孕妇长期处在超过50分贝的噪音环境中,会使内分泌腺体功能紊乱,并出现精神紧张和内分泌系统失调。严重的会使血压升高、胎儿缺氧缺血、导致胎儿畸形甚至流产。而高分贝噪音能损坏胎儿的听觉器官,致使部分区域受到影响。影响大脑的发育,导致儿童智力低下。
噪音的恶性刺激,严重影响我们的睡眠质量,并会导致头晕、头痛、失眠、多梦、记忆力减退、注意力不集中等神经衰弱症状和恶心、欲吐、胃痛、腹胀、食欲呆滞等消化道症状。营养学家研究发现,噪音还能使人体中的维生素、微量元素、氮基酸、谷氮酸、赖氮酸等必需的营养物质的消耗量增加,影响健康;噪音令人肾上腺分泌增多心跳加快、血压上升,容易导致心脏病发;同时噪音可使人唾液、胃液分泌减少,胃酸降低,从而患胃溃疡和十二指肠溃疡。